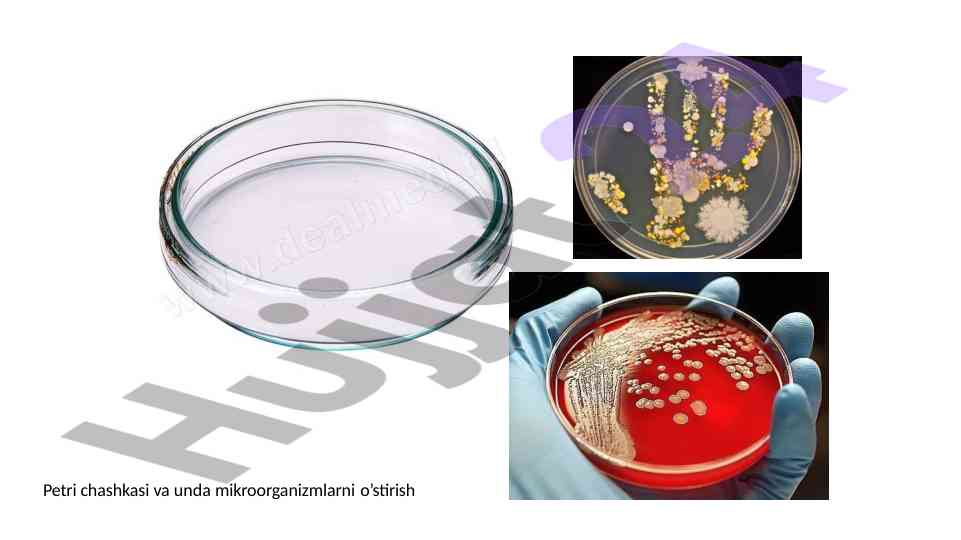

Mikrobiologik tadqiqotlar asosiy usullari bo'yicha dars

Hu
Muallif:
Hujjat Sifati
Hujjat ma'lumotlari
Kategoriya:
Taqdimotlar (slaydlar) Format:
pptx Sahifalar:
30 bet Ko'rilgan:
1 marta Sotilgan:
0 marta Hajmi:
3.07 MB Narxi:
5,000 so'mMahsulot tavsifi:
Mikrobiologiya va virusologiya faniga oid tadqiqotlar, uskunalar va usullar haqida dars rejasi. Mikroskopiya, serologik va bakteriologik usullarning qo'llanilishi.










